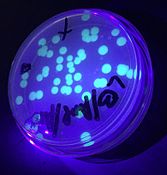

- BioVector NTCC典型培养物保藏中心
- 联系人:Dr.Xu, Biovector NTCC Inc.
电话:400-800-2947 工作微信:1843439339 (QQ同号)
邮件:Biovector@163.com
手机:18901268599
地址:北京
- 已注册
pGLO plasmid
Overview
Green fluorescent protein (GFP) is a protein that glows with a bright green fluorescence when exposed to ultraviolet light. The gene sequence coding for GFP was first isolated from the marine jellyfish Aequorea victoriaand has since been widely used in cellular and molecular biology as a reporter to detect gene expression in transgenic organisms. The pGLO plasmid contains the GFP gene and other functional DNA sequences that enable its use for bacterial transformation and expression.
Right:Bacteria transformed with pGLO visualized under ultraviolet light
Right:Bacteria transformed with pGLO exposed to ampicillin and ultraviolet light
pGLO Gene Regulation: One Gene, One Protein?
Our bodies contain thousands of different proteins, which perform many different jobs. Digestive enzymes, some of the antibodies protecting us from disease, and the hormone signals that run through our bodies are all proteins. The information for assembling a protein is carried in our DNA. The section of DNA that contains the code for making a protein is called a gene. There may be up to 100,000 genes in the human genome. Each gene codes for a unique protein: one gene, one protein. The gene that codes for a digestive enzyme in your mouth is different from one that codes for an antibody or a pigment that colors your eyes.
Organisms regulate the expression of their genes and, ultimately, the amounts and kinds of proteins present within their cells, for a myriad of reasons, including development, cellular specialization, and adaptation to the environment. Gene regulation not only allows adaptation to differing conditions but also prevents wasteful overproduction of unneeded proteins, which would put the organism at a competitive disadvantage. The genes involved in the transport and breakdown (catabolism) of food are good examples of highly regulated genes. For example, the sugar arabinose is both a source of energy and a source of carbon. E. coli bacteria produce three enzymes (proteins) needed to digest arabinose as a food source. The genes that code for these enzymes are not expressed when arabinose is absent, but they are expressed when arabinose is present in their environment. How is this so?
Regulation of protein expression often occurs at the level of transcription from DNA into RNA. This regulation takes place at a very specific location on the DNA template, called a promoter, where RNA polymerase binds the DNA and begins transcription of the gene. In bacteria, groups of related genes are often clustered together and transcribed into RNA from one promoter. These clusters of genes controlled by a single promoter are called operons.
The three genes that code for the three digestive enzymes involved in breaking down arabinose (araB, araA, and araD) are clustered together in what is known as arabinose operon 3. These three proteins depend on initiation of transcription from a single promoter, pBAD. Transcription of these three genes requires the simultaneous presence of the DNA template (promoter, gene, and operon), RNA polymerase, a DNA-binding protein called AraC, and arabinose. The AraC protein binds to the DNA at the binding site for RNA polymerase (the beginning of the arabinose operon).
When arabinose is present in the environment, bacteria take it up. Once inside, the arabinose interacts directly with AraC, which is bound to the DNA. The interaction causes AraC to change shape, which in turn helps RNA polymerase bind the promoter, and the three genes araB, araA, and araD are transcribed. Three enzymes are produced; they do their job to break down arabinose, and eventually the arabinose runs out.
The DNA sequence of the pGLO plasmid has been engineered to incorporate aspects of the arabinose operon. Both the promoter (pBAD) and the araC gene are present. However, the genes that code for arabinose catabolism (araB, araA, and araD) have been replaced by the single gene that codes for the green fluorescent protein (GFP), which serves as a reporter gene. In the presence of arabinose, the AraC protein promotes the binding of RNA polymerase to the promoter, which causes the transciption of the GFP gene into messenger RNA (mRNA), followed by the translation of this mRNA into GFP; this process is called gene expression.
As they produce more and more protein, the cells expressing GFP fluoresce a brilliant green. In the absence of arabinose, AraC no longer facilitates the binding of RNA polymerase, and the GFP gene is not expressed. When the GFP protein is not made, bacterial colonies will appear to have a wild-type (natural) phenotype — of white colonies with no fluorescence. This is an excellent example of the central dogma of molecular biology in action: DNA > RNA > protein > trait.
pGLO contains several DNA sequences that enable replication of the plasmid DNA and expression of the fluorescent trait (phenotype) in bacteria following transformation. The essential sequences include the following:
GFP— the jellyfish gene that codes for the production of green fluorescent protein
bla — a gene that encodes the enzyme beta-lactamase, which breaks down the antibiotic ampicillin. Bacteria containing the bla gene can be selected by placing ampicillin in the growth medium.
ori — the origin of pGLO plasmid DNA replication
araC — a gene that encodes the regulatory protein that binds to the pBAD promoter. Only when arabinose binds to the AraC protein is the production of GFP switched on.
pBAD promoter — a specific DNA sequence upstream from the GFP gene, which binds araC-arabinose and promotes RNA polymerase binding and transcription of the GFP gene.
Multiple cloning site — a region containing restriction sites (NdeI, HindIII, EcoRI, etc.), sequences that permit the insertion or deletion of the gene of interest

BioVector NTCC质粒载体菌种细胞基因保藏中心
您正在向 biovector.net 发送关于产品 pGLO原核荧光表达载体阿拉伯糖诱导表达-BioVector NTCC质粒载体菌种细胞基因保藏中心 的询问
- 公告/新闻